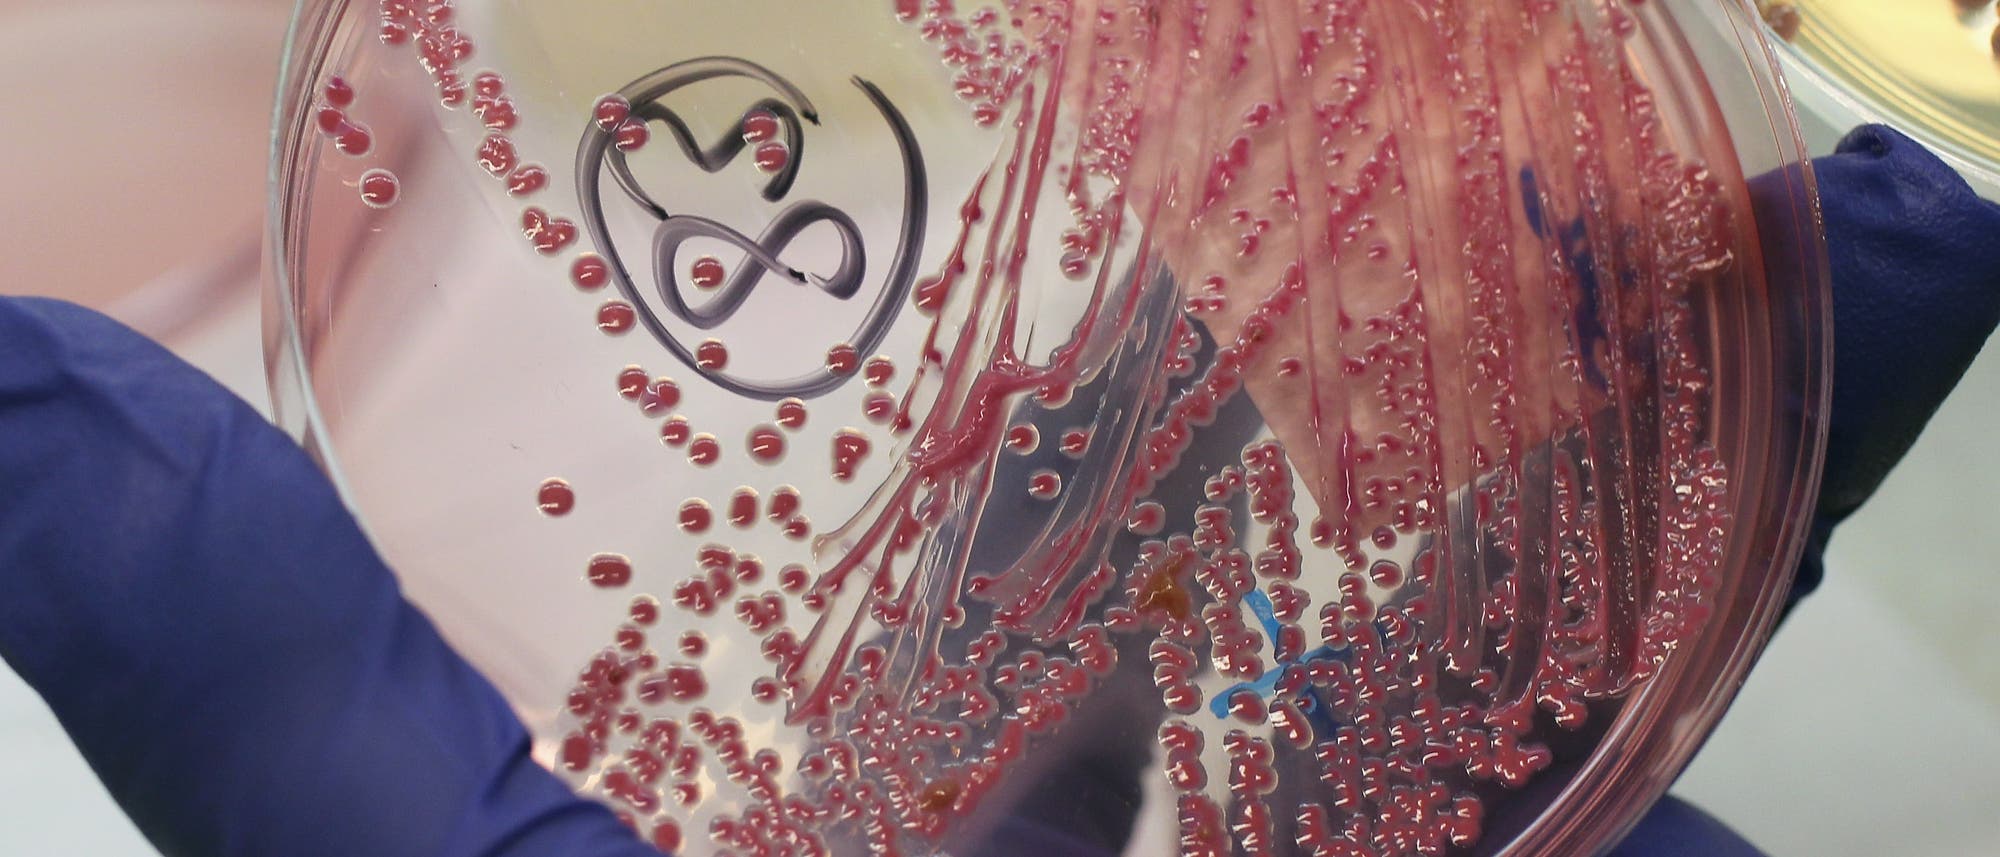
Eine Hand in einem blauen Handschuh hält eine Petrischale mit einer EHEC-Bakterienkultur. Im Hintergrund sieht man in Unschärfe einen typischen Laborhintergrund. Eine Hand in einem blauen Handschuh hält eine Petrischale mit einer EHEC-Bakterienkultur. Im Hintergrund sieht man in Unschärfe einen typischen Laborhintergrund.

Durchfallerkrankungen: Ursache für Ehec-Ausbruch im Nordosten weiterhin unklar
Dieser Inhalt wurde automatisch von der Deutschen Presse-Agentur (dpa) übernommen und von Spektrum.de nicht redaktionell bearbeitet.
Die Suche nach den Gründen für das gehäufte Auftreten von Ehec-Infektionen in Mecklenburg-Vorpommern mit oft schwerem Krankheitsverlauf hat bislang keine greifbaren Ergebnisse gebracht. Weder lasse sich der Ausgangsort genau lokalisieren, noch sei die Infektionsquelle identifiziert, sagte Gesundheitsministerin Stefanie Drese (SPD) in Schwerin.
Anfang August waren in Vorpommern bei Einheimischen und Feriengästen die ersten schweren Durchfallerkrankungen aufgetreten. Die Infektionen führten dazu, dass vorwiegend Kinder stationär behandelt werden mussten, teilweise auf Intensivstationen der Krankenhäuser.
Das Ausbruchsgeschehen halte nun schon seit mehr als einem Monat an. »Und je länger wir diesen Bakterienstamm in Mecklenburg-Vorpommern haben, umso schwieriger wird es auch, beprobbare Lebensmittel aufzufinden oder sich zu erinnern, wann habe ich wo etwas gegessen«, erklärte die Ministerin.
Verschiedenen Infektionswege möglich
Ehec steht für Enterohämorrhagische Escherichia coli – bestimmte krank machende Stämme eines Darmbakteriums, das vor allem bei Wiederkäuern vorkommt. Es kann etwa durch direkten Kontakt zu Tieren oder den Verzehr kontaminierter Lebensmittel auf den Menschen übertragen werden. Von der Ansteckung bis zum Ausbruch der Krankheit kann es bis zu zehn Tage dauern.
Die Mikroben produzieren starke Zellgifte, die bei Menschen schwere Durchfallerkrankungen hervorrufen. Bei besonders schwerem Verlauf kann es auch zu Blutgerinnungsstörungen und Funktionsstörungen der Nieren kommen.
Anfang September war der für den Ausbruch in MV verantwortliche Bakterienstamm identifiziert worden, der nach Angaben der Ministerin besonders aggressiv und zudem eher selten in Europa zu finden sei. Das hatte Hoffnungen geschürt, endlich auch die Infektionsquelle zu finden.
Ursachensuche als Sisyphusaufgabe
Die Betroffenen seien ausführlich zu Aufenthaltsorten und verspeisten Lebensmitteln befragt worden. Die Antworten abzugleichen, Parallelen festzustellen und daraus eine mögliche Infektionsquelle abzuleiten, gleiche einer Sisyphusaufgabe, sagte Drese. »Bei dem großen Ehec-Ausbruch 2011 hat es über acht Wochen gedauert, bis man so ungefähr eine Ahnung hatte, woher es kommt«, rief sie in Erinnerung. Die wahrscheinliche Ursache damals: verunreinigte Sprossen von Bockshornklee-Samen aus Ägypten.
Seit Beginn des Ehec-Ausbruchs in Mecklenburg-Vorpommern registrierten die zuständigen Behörden im Land bislang 78 Fälle. Davon gehen nachweislich 21 auf den besagten Bakterienstamm zurück. Die restlichen 57 Erkrankungen werden als Verdachtsfall geführt. Mecklenburg-Vorpommern ist Zentrum des Ausbruchsgeschehens, dem die Behörden bundesweit 89 Infektionen zurechnen.
Ehec-Ansteckungen gibt es regelmäßig. Daten des Robert Koch-Instituts zufolge wurden 2023 bundesweit mehr als 3440 Erkrankungen erfasst, 2024 rund 4570 und in diesem Jahr bis Ende August etwa 3700. Im Jahr 2023 wurden fünf Todesfälle gemeldet, die auf das hämolytisch-urämische Syndrom (HUS) zurückgingen, im Jahr 2024 waren es drei.
Wenn Sie inhaltliche Anmerkungen zu diesem Artikel haben, können Sie die Redaktion per E-Mail informieren. Wir lesen Ihre Zuschrift, bitten jedoch um Verständnis, dass wir nicht jede beantworten können.